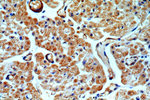
ADCY3 Antibody in Immunohistochemistry (Paraffin) (IHC (P))

Search
Proteintech
ADCY3 Polyclonal Antibody
{{$productOrderCtrl.translations['antibody.pdp.commerceCard.promotion.promotions']}}
{{$productOrderCtrl.translations['antibody.pdp.commerceCard.promotion.viewpromo']}}
{{$productOrderCtrl.translations['antibody.pdp.commerceCard.promotion.promocode']}}: {{promo.promoCode}} {{promo.promoTitle}} {{promo.promoDescription}}. {{$productOrderCtrl.translations['antibody.pdp.commerceCard.promotion.learnmore']}}
产品信息
19492-1-AP
种属反应
已发表种属
宿主/亚型
分类
类型
抗原
偶联物
形式
浓度
规格
纯化类型
保存液
内含物
保存条件
运输条件
靶标信息
This gene encodes adenylyl cyclase 3 which is a membrane-associated enzyme and catalyzes the formation of the secondary messenger cyclic adenosine monophosphate (cAMP). This protein appears to be widely expressed in various human tissues and may be involved in a number of physiological and pathophysiological metabolic processes.
仅用于科研。不用于诊断过程。未经明确授权不得转售。
生物信息学
蛋白别名: AC-III; AC3; Adenylate cyclase type 3; Adenylate cyclase type III; Adenylate cyclase, olfactive type; Adenylyl cyclase 3; adenylyl cyclase, type III; ATP pyrophosphate-lyase 3; type III adenylyl cyclase; unnamed protein product
基因别名: AC-III; AC3; ADCY3; BMIQ19; KIAA0511; mKIAA0511
UniProt ID: (Human) O60266, (Rat) P21932, (Mouse) Q8VHH7
Entrez Gene ID: (Human) 109, (Rat) 64508, (Mouse) 104111